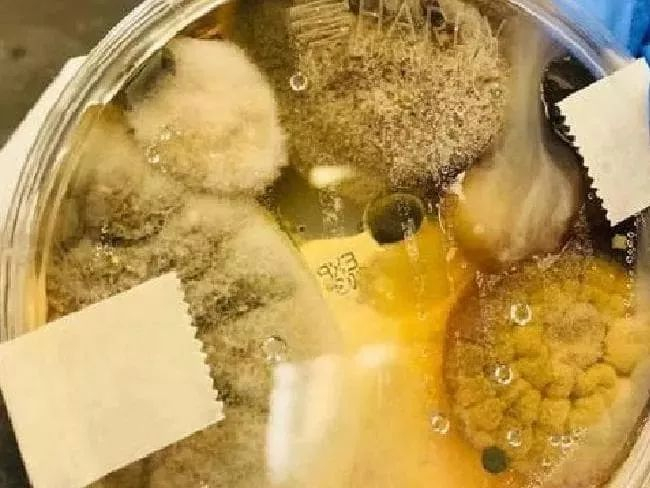

来源:今日墨尔本
最好看的新闻,最实用的信息。
今日话题
对于每个旅行者而言,
机场无疑是再熟悉不过的地方了。
每天,
它都承载着无数旅客的
出发和抵达。
可今天,
澳媒7News揭露了一个可怕的真相!
其实,机场和飞机上的许多设施
远比我们想象中要脏的多!


情况非常不容乐观,
有些设施
甚至比家用马桶圈
脏了近10000倍!
更可怕的是,
这些东西大家都可能碰过!
01
它比你家的马桶圈要脏1万倍!
眼看着澳洲越来越冷,国内越来越热,不少人开始蠢蠢欲动地谋划起了出门旅游度假。
“航空运输”几乎成为了大家出远门的首选出行方式。

可就在这个节骨眼上,澳媒7News却爆出了一件细思极恐的事情。
你有没有一出国玩就生病?
赶飞机后常常感到不舒服?
如果是的话,那可能是空气中的无处不在的细菌导致,
而原因也许是你在机场或是飞机上
曾经碰触过这些东西!
第一名:自助值机屏幕
据insuranceQuotes.com针对美国最繁忙的三大机场和航班飞机上的设施进行了细菌和真菌数量抽样检测。
结果显示,机场最脏的地方竟然就是自助值机设备。

在针对机场6台自助值机设备的屏幕上菌落数量进行了18次抽样对比后,
震惊的发现,其中一台自助值机屏上的每平米菌落数就超过了100万CFU。

而其他自助值机屏上的菌落数也高达平均数值253,857CFU。
要知道,生活家用马桶圈上每平米的菌落数也仅有172 CFU!

而这些值机设备上的菌落数量,
超过家用马桶圈
细菌数量近一万倍!

看来,自助值机设备的屏幕绝对是机场最“脏”的地方。
但它们绝不是机场
唯一滋生细菌的地方!
如果说,旅客选择人工值机的方式出票,就可以有效的避免接触大量细菌。


那么接下来的第二,第三名,就有点让大家措手不及了。
第二名:候机室长椅扶手
坐在候机室的长椅上等待登机,是我们每个旅客大都会做的事情。
有时候累了,还有人会躺在候机室的长椅上睡觉。

但是,大家不知道的是候机室长椅非常的“脏”,菌落的平均数量并不比第一名差多少。
特别是椅子的扶手部分,每平米菌落数高达21,630CFU。

会有乘客吃过东西后在上面擦手,甚至有部分乘客上过厕所后会忘了洗手,然后触摸扶手。
所以,下次当你想触摸扶手时,请三思而后行哟!
第三名:喷泉式饮水器按钮
再来看看,机场不幸登上第三名“脏”的设施是哪个?
出人意料的是,竟然是喷泉式饮水器的按钮,它每平方的菌落数高达19,181CFU。

当你在喝水的时候,其实双手接触了大量的细菌,稍不留神很可能“度假”变“病假”了。

那么问题来了,只要注意了机场里最“脏”的前三名设施,就可以远离细菌威胁了吗?
02
你再猜猜飞机上最脏的地方是哪?
检测晚了机场的公共设施,调查人员还对飞机上的设施进行了检查。

结果不出所料,人流量密集的飞机上也有不少“雷区”,而且大多数人都会接触到这些地方!
第一名:洗手间冲水按钮
其实,每次坐飞机去上厕所,都赶紧尿完赶紧走……
因为飞机上的洗手间从气味都体验都非常差,从这一点就能看出那里充斥着不少细菌。

检测结果不出所料,飞机洗手间中的冲水按钮是旅客可以触及到的最脏的地方,每平米平均菌落数量为95,145CFU。

你们说说,谁还没有在飞机上厕所的经历呀,原来,无形之中大家都接触了大量的细菌。

第二名:折叠小桌板
此次检测结果显示,飞机上第二“脏”的地方就是折叠小桌板!

据悉,每块折叠小桌板上的菌落单位数达到了11,595CFU。

没错,就是离你最近的那一块塑料,你还在上面吃吃喝喝甚至趴着睡觉呢!
第三名:安全带扣
更让人意外的是,安全带的扣环居然比厕所的门锁还脏!

结果显示,乘客使用的安全带扣上的每平米菌落数量也达到了1,116CFU。

其实这个结果并不令人意外,安全带扣早已被触摸了成千上万次,但其实很少会被清洗或更换。

而乘客却在无形中不得不接触到各种细菌,如果没有勤洗手的习惯,很可能交叉感染一些疾病。
03
发现细菌对人体可能造成的危害
目前,Tigerair和Virgin Australia两家航空公司都表示:我们会“定期”清洁。
但每家航空公司的清洁频率及程度都不相同,特别是转机时间较短的航班,飞机是来不及清洁的。

即使对飞机进行了清洁,能够达到的杀菌效果也令人担忧。
因为,调查人员在检测发现的多种细菌中,发现了革兰氏阳性球菌(gram-positive cocci)。

这是一种会加速感染,引发化脓性炎症的细菌。


其中,厕所冲水按钮上检测出革兰氏阳性球菌,占有82%。自助值机屏上,则占有53%比例。

不仅如此,餐桌表面附着细菌还占有1/3的芽孢杆菌(Bacillus),可能导致食物变质引起疾病。

尽管研究人员承认细菌无处不在,而且在许多情况下是不可避免的。
04
7招教你如何好好坐飞机
是不是已经被吓尿了?这么多细菌还让不让我们好好搭飞机了!
大家不要怕,今日哥为了大家的出行健康安全,贴心的整理了7招应对良策。
下次乘飞机旅行,
再也不用担心健康可能受到威胁啦~
1)用飞机上的枕头和毯子需谨慎
还在使用飞机上的毯子和枕头吗?你如果知道航空公司大概每隔5~30天才会清洗一次客用毯子和枕头,你就会知道它有多脏了!

2)接触折叠餐桌风险大
前文说过,折叠小桌板是飞机上第二脏的地方,所以千万不要吃掉在上面的食物。

3)别把自己的物品放在椅背袋
要记住,上一位乘客很可能在椅背袋里放过各种东西,垃圾、尿布、甚至呕吐袋。。。而大肠杆菌等细菌可以在这些地方存活好几天。

4)最好点一份热餐
因为飞机餐大都是速冻储藏,很难保证你点的一份色拉或冷面是否受到了细菌感染,为了确保万无一失,选择一份经过高温杀菌的食物更安全。

5)不要看飞机上的杂志
想一想,一本经过无数乘客翻阅过的杂志,你能能保证他们的手都是干净的吗?如果想打发时光,可以在候机楼提前买一本。

6)湿纸巾来帮忙
湿巾纸绝对是我们出门旅行的必备佳品,在入座后,只要使用湿纸巾把座椅扶手,小桌板等,其他乘客常常接触的地方擦一下,就好啦!

7)便携式洗手液消毒
每天,我们的双手都必须接触各种东西,必然沾染了不少细菌,如果你正好坐在靠窗的位置,洗手不方便的话,此时便携式洗手液就帮大忙了。

当然,生活中的细菌无处无在,今日哥也并不是提倡大家谈虎色变。
但是,提前做好力所能及的预防措施,是对自己,也是对家人的负责。
今日结语
真的是意想不到,
原来每天人来人往的机场和机舱里,
潜伏者这么多肉眼看不见的威胁。
而这些细菌,
很可能在我们疏忽大意之时,
危害到我们的健康。
所以下次出门在外,
大家还是要保持勤洗手的习惯哦!
祝大家都能有一个完美的悠长假期!
来源:今日悉尼

本文作者系新浪国际旗下“地球日报”自媒体联盟成员,授权稿件,转载需获原作者许可。文章言论不代表新浪观点。

